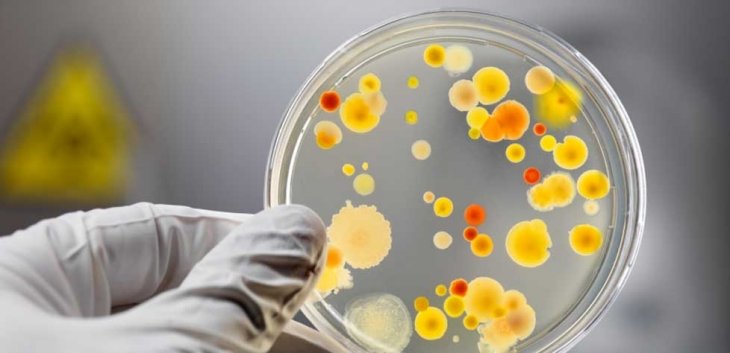

Останні новини
Нероби за гороскопом — четвірка найбільш ледачих знаків ЗодіакуКілька порад, які допоможуть чоловікам покращити спілкування з дружинамиЯкщо зникнуть інтернет, зв'язок, радіо і ТБ: у Львові навчають, як діяти в надзвичайних ситуаціяхНезаконно літав у Крим: на Львівщині прикордонники не пропустили в Україну росіянина"Проводили спалювання під наглядом": в ДСНС прокоментували задимлення в Генконсульстві РФ у ЛьвовіВ екстреному порядку: Австралія закрила посольство у ЛьвовіГенеральне консульство Росії у Львові призупинило роботуТОП-3 знаки Зодіаку, для яких ця весна стане найважчоюЯкий копійчаний компонент додати в шампунь, щоб не мити голову щодняЕстонська розвідка показала карту, на якій Львів позначений ціллю для ймовірного обстрілу з боку російських військУ Львові стався обвал у житловому будинку: люди відмовилися від евакуаціїНідерланди переводять своїх дипломатів з Києва до Львова«Обманом змусили дути в драгер»: депутата зі Львівщини 4 рази впіймали п'яним за кермом67-річна жінка 3 місяці ходила зі зламаним хребтом і навіть не підозрювала про цеМеновазин: особливості застосування та ефективність препарату*Львівські бабаки дали свої прогнози на прихід весниУ Львові лікар протягнув зубами швидку, щоб привернути увагу до щеплення проти поліомієліту: відеоЯк знаки зодіаку створюють собі проблеми і псують життя — це допоможе зрозуміти корінь ваших проблемУ якому напрямку біжить людина? Тест покаже,як ви думаєте – чоловік або як жінкаБританія вслід за США переводить своїх дипломатів до Львова«Евакуація» до Львова: місцева влада розповіла, чи просили іноземні посольства виділити їм приміщення
Авторизація
Календар публікацій
| « Квітень 2026 » | ||||||
|---|---|---|---|---|---|---|
| Пн | Вт | Ср | Чт | Пт | Сб | Нд |
| 1 | 2 | 3 | 4 | 5 | ||
| 6 | 7 | 8 | 9 | 10 | 11 | 12 |
| 13 | 14 | 15 | 16 | 17 | 18 | 19 |
| 20 | 21 | 22 | 23 | 24 | 25 | 26 |
| 27 | 28 | 29 | 30 | |||
09 лют 13:30Новини Львів / Ситуації
У Львові зафіксовано кишкове отруєння серед відвідувачів ресторану "Нью-Йорк стріт піца"
Розпочато проведення комплексу протиепідемічних заходів щодо розслідування та локалізації спалаху.
Серед відвідувачів ресторану «Нью-Йорк стріт піца» на території ТЦ «Шувар» у Львові зафіксовано отруєння.
До інфекційних відділень лікарень з діагнозом «гостра кишкова інфекція» госпіталізовано 6 осіб, зокрема 3 дітей, повідомляє УНІАН.
Невідкладно розпочато проведення комплексу протиепідемічних заходів щодо розслідування та локалізації спалаху. Проведено перевірку закладу громадського харчування, з яким постраждалі пов’язують своє захворювання.
Встановлено, що організацію харчування, згідно з договором суборенди, здійснює ФОП Гладун І.В. У ході перевірки відібрано проби для проведення відповідних лабораторних досліджень, обстежено персонал закладу.
Ситуація перебуває на контролі Головного Управління Держпродспоживслужби у Львівській області.
Читайте також:
Стало відомо, чим отруїлися працівники Укрзалізниці на корпоративі у ЛьвовіНоворічний корпоратив "Укрзалізниці" завершився масовим харчовим отруєннямКількість постраждалих після бенкету у львівському ресторані зросла до 21 особиЧетверо людей потрапили до лікарні через отруєння у ресторані ЛьвоваКопчена риба вклала на лікарняні ліжка вже 28 львів'ян
Додати коментар
КАРТИНА ДНЯ
Новини партнерів
Відео матеріали
Ми у соцмережах